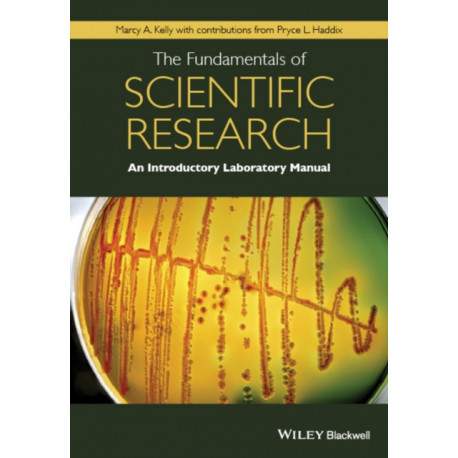
The Fundamentals of Scientific Research: An Introductory Laboratory Manual

Kurv
Vare
varer
(tom)
Ingen varer
Fastlægges senere
Forsendelse
0,- kr
I alt
The Fundamentals of Scientific Research: An Introductory Laboratory Manual
(Bog, Paperback / softback, Engelsk)
Forlag:
John Wiley and Sons Ltd
- Type: Bog
- Format: Paperback / softback
-
Sprog:
Engelsk

- ISBN-13: 9781118867846
- Se flere detaljer ▼
Bemærk: Kan ikke leveres før jul.
Beskrivelse
The Fundamentals of Scientific Research: An Introductory Laboratory Manual is a laboratory manual geared towards first semester undergraduates enrolled in general biology courses focusing on cell biology.
Læsernes anmeldelser (0)
Alle detaljer
| Forlag | John Wiley and Sons Ltd |
| Forfatter | Marcy A. Kelly |
| Type | Bog |
| Format | Paperback / softback |
| Sprog | Engelsk |
| Udgivelsesdato | 26-02-2016 |
| Første udgivelsesår | 2016 |
| Originalsprog | United Kingdom |
| Sideantal | 208 |
| Indbinding | Paperback / softback |
| Forlag | John Wiley and Sons Ltd |
| Sideoplysninger | 208 pages |
| Mål | 245 x 278 x 16 |
| ISBN-13 / EAN-13 | 9781118867846 |

